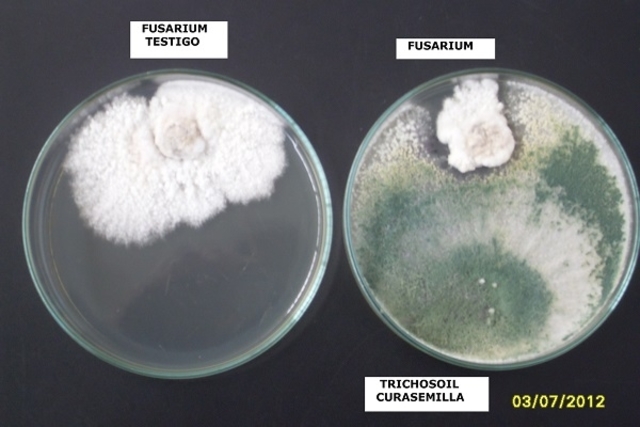
New y Kerr. Primero controlador biológico.

-
Primer estudio de enfermedades en árboles, cereales y leguminosas (Agrios, 2005).
-
Partícula de polvo tomadas de un hongo e inoculadas en frutas, producían la misma clase de hongo (Agrios, 2005).
-
Este cientifico demostró que el llamado "carbón cubierto", era ocasionado por un hongo (Agrios, 2005).
-
Destrucción de cultivos de papa por esta plaga, ocasionó la hambruna en Irlanda y otros países Europeos (Agrios, 2005).
-
Se demostró por experimentos que el agente causal de la enfermedad que arrasó con cultivos de papa en Europa fue Phytophthora infestans (Agrios, 2005).
-
Desarrollo tecnicas modernas de cultivos de micoorganismos para así poder obtener cultivos puros. (Agrios, 2005).
-
Determinó que mezclas de quimicos como: sulfato de cobre y cal hidratada; eran capaces de controlar de manera eficiente el mildiu de la vid (Agrios, 2005).
-
Se descubrió el primer fungicida de ditiocarbamatos, que desarrollo por los diez sigueintes años.
-
Se encontró cepas de hongos fitopatógenos resistentes a fungicidas (Agrios, 2005).
-
Se introdujo el primer control biológico. Observando resultados positivos inoculando otra bacteria en una planta que tenía la enfermedad llamada "agalla de la corona" (Agrios, 2005).
Plan projects on a visual timeline
Map milestones, phases, deadlines, and key events in one place so the sequence is easier to see and share. Timetoast is a timeline maker for work, school, research, and stories.